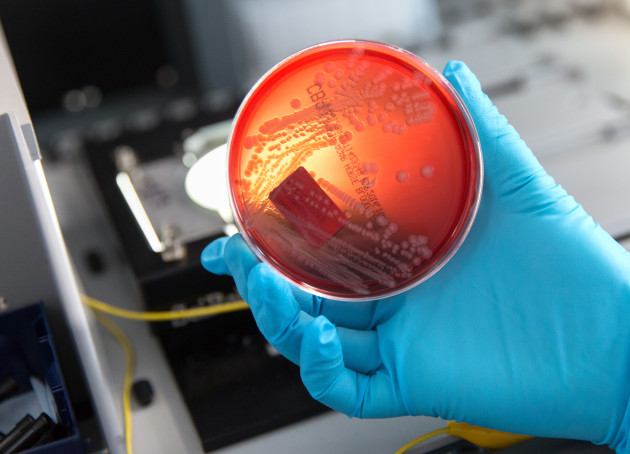

If your passion is science and you're looking for something inspiring to read, take a look at our recommended reading list. Below is a list of favourite books suggested by our staff, ambassadors and academics.
These books are available to purchase online and at major bookstores, and most will be available from your local library. We hope you enjoy it!
Once you've read a book on our recommended reading list why not rate it?
Book list
A short history of nearly everything by Bill Bryson
Suggested by Richard Brown, Reach Out Makerspace Technician
 Best known for his humorous travel books, this is a slight detour for the author, but one that is filled with the engaging enthusiasm of someone discovering science in all its wonder and peculiarities [plus some luck, bizarre occurrences and tragedy] as if travelling a new continent. This is by no means a heavy tone but you will find yourself educated and entertained. I would repeatedly find myself so engrossed in its pages, many times reading into the small hours of the morning.
Best known for his humorous travel books, this is a slight detour for the author, but one that is filled with the engaging enthusiasm of someone discovering science in all its wonder and peculiarities [plus some luck, bizarre occurrences and tragedy] as if travelling a new continent. This is by no means a heavy tone but you will find yourself educated and entertained. I would repeatedly find myself so engrossed in its pages, many times reading into the small hours of the morning.
8000 metres climbing the world's highest mountains by Alan Hinkes
Suggested by Manish Patel, Document Delivery Coordinator, Library Services

The book is primarily about adventurer mountaineering, climbing the world's highest mountains. The themes covered within it include the natural environment, Climates, Geology and Geography. Human physiology, endurance; survival in extreme conditions. The author, previously working as a teacher, became an international mountain guide and accomplished reaching the highest summits. The book adds inspiration to the subjects and a spirit of adventure others might want to pursue.
The Science Book, Big Ideas Simply Explained by by Rob Colson (Editor), Camilla Hallinan (Editor), David John (Editor), Adam Hart-Davis
Suggested by Zhendan Shang, Postgraduate Earth Science & Engineering
 I would like to recommend this book because I thought that it was a really good read. The book showcased the ingenuity of humanity in exploring and understanding the wonders of the world around them, the various methods that the great minds of the past used to investigate the world, and the thinking behind various facts that we may take for granted today. I also like that it covers a wide range of topics in science, from biology, physics, chemistry to geology, gives an outline of the history of how we reached our current understanding of the world, and touches on the latest advances in the scientific domain where active research is currently being done. I think its greatest selling point is that it instils a scientific method of how to think critically about nature with lots of quirky drawings and diagrams. It's a really good starting point for anyone generally curious about the natural world and how our current knowledge of the world came to be.
I would like to recommend this book because I thought that it was a really good read. The book showcased the ingenuity of humanity in exploring and understanding the wonders of the world around them, the various methods that the great minds of the past used to investigate the world, and the thinking behind various facts that we may take for granted today. I also like that it covers a wide range of topics in science, from biology, physics, chemistry to geology, gives an outline of the history of how we reached our current understanding of the world, and touches on the latest advances in the scientific domain where active research is currently being done. I think its greatest selling point is that it instils a scientific method of how to think critically about nature with lots of quirky drawings and diagrams. It's a really good starting point for anyone generally curious about the natural world and how our current knowledge of the world came to be.
STEM Book List General Science (PDF)
Photo 1 by Colin Behrens from Pixabay; Photo 2 from Pixabay; Photo 3 by Thomas Angus Imperial College London
Why evolution is true by Jerry Coyne
Katherine Davis, Research Postgraduate School of Public Health
 I read "Why Evolution is True" for the first time after I decided to study biology at university. I loved the way Coyne weaves together different fields, including genetics, molecular biology and anatomy, with colourful and interesting examples from across the living world. Everything is linked in a clear and accessible way to the central argument - Coyne takes a true scientist's approach as he tours the evidence and examines the details. Reading this book, I began to understand how evolution is the golden thread tying together all of the fields of biology - it changed my perspective on the natural world. If you're interested in studying biology, or understanding evolution, I would thoroughly recommend picking up this book!
I read "Why Evolution is True" for the first time after I decided to study biology at university. I loved the way Coyne weaves together different fields, including genetics, molecular biology and anatomy, with colourful and interesting examples from across the living world. Everything is linked in a clear and accessible way to the central argument - Coyne takes a true scientist's approach as he tours the evidence and examines the details. Reading this book, I began to understand how evolution is the golden thread tying together all of the fields of biology - it changed my perspective on the natural world. If you're interested in studying biology, or understanding evolution, I would thoroughly recommend picking up this book!
The blind watchmaker by Richard Dawkins
Suggested by Dr Jenny Cooke, Mentoring and Tutoring Programme, Manager
 The Blind Watchmaker explores the theory of evolution and was published after Dawkin's most well- known book, The Selfish Gene (where the term meme is first used!). I read it when I was studying A levels and found it really clear and easy to read. I loved reading a book about science that contained lots of scientific facts and information but also used examples and eloquent writing to form persuasive arguments. The simple descriptions taught at school around natural selection make sense but when you look at the world and the amazing complexity of living creatures it does sometimes seem impossible that this could happen by chance - this book gives you confidence that this could happen! I have read a few of Dawkin's later books which I found a little too strong in their anti-creationist arguments but this book balances this well.
The Blind Watchmaker explores the theory of evolution and was published after Dawkin's most well- known book, The Selfish Gene (where the term meme is first used!). I read it when I was studying A levels and found it really clear and easy to read. I loved reading a book about science that contained lots of scientific facts and information but also used examples and eloquent writing to form persuasive arguments. The simple descriptions taught at school around natural selection make sense but when you look at the world and the amazing complexity of living creatures it does sometimes seem impossible that this could happen by chance - this book gives you confidence that this could happen! I have read a few of Dawkin's later books which I found a little too strong in their anti-creationist arguments but this book balances this well.
The omnivore’s dilemma: A natural history of four meals by Michael Pollan
Suggested by Joanna L Clasen, Research Postgraduate School of Public Health
 As a fan of cooking, and food in general, I found this book to be a fascinating read. It cuts across disciplines and shows the interwoven complexity of how science, economics, and culture influence our diets. The author takes a seemingly ordinary topic and turns it into an interesting and easy read. I am a student working in nutritional epidemiology, and I love books that provide a different perspective on food and nutrition.
As a fan of cooking, and food in general, I found this book to be a fascinating read. It cuts across disciplines and shows the interwoven complexity of how science, economics, and culture influence our diets. The author takes a seemingly ordinary topic and turns it into an interesting and easy read. I am a student working in nutritional epidemiology, and I love books that provide a different perspective on food and nutrition.
The private life of plants by David Attenborough
Suggested by Dr Annalisa Alexander, Head of Outreach
 I’ve always been fascinated by plants ever since I was very young when someone gave me a Venus Fly Trap. Watching it catch flies (and perhaps over triggering it with a little prod here and there) made me want to know why it did it and what it did with the fly once its ‘jaws’ had closed. I watched the TV series that accompanied this book many years ago and I was amazed at just how incredible plants truly are. The book takes you through every part of a plant’s life cycle, using examples, stunning photography and astounding facts. If you think that they are just boring green things that grow, make flowers, look nice and get us out of a trouble when we’ve forgotten a birthday, think again…. You’ll learn just how sophisticated some are, how they can replicate insect pheromones or produce ultra violet light to attract the right pollinators, aggressively stop other plants encroaching on their space and actually repel other organisms with a hideous stench. I challenge you NOT to be amazed by just how highly evolved some plants are. You’ll never look at an orchid in the same light…. Literally…
I’ve always been fascinated by plants ever since I was very young when someone gave me a Venus Fly Trap. Watching it catch flies (and perhaps over triggering it with a little prod here and there) made me want to know why it did it and what it did with the fly once its ‘jaws’ had closed. I watched the TV series that accompanied this book many years ago and I was amazed at just how incredible plants truly are. The book takes you through every part of a plant’s life cycle, using examples, stunning photography and astounding facts. If you think that they are just boring green things that grow, make flowers, look nice and get us out of a trouble when we’ve forgotten a birthday, think again…. You’ll learn just how sophisticated some are, how they can replicate insect pheromones or produce ultra violet light to attract the right pollinators, aggressively stop other plants encroaching on their space and actually repel other organisms with a hideous stench. I challenge you NOT to be amazed by just how highly evolved some plants are. You’ll never look at an orchid in the same light…. Literally…
Photo 1 by Arpat Ozgul Imperial College London; Photo 2 by Beth Elzer Imperial College London; Photo 3 by Jerzy Górecki from Pixabay; Photo 4 by Thomas Angus Imperial College London
The disappearing spoon by Sam Kean
Suggested by Daisy Rogers-Simmonds, Research Postgraduate Chemistry
 I recommend this book for anyone with an interest in chemistry. The author takes you on a tour of the periodic table, showcasing how a variety of elements from the notorious to the obscure have driven advancements in chemistry. The author places an emphasis on how these advancements in chemistry have impacted health, politics, economics, war and technology – and how it has not always, knowingly or unknowingly, been used for good. A focus on the societal impact of chemistry is effectively used as a vehicle to introduce higher-level concepts in chemistry that reach beyond the syllabus. The main reason that I really love this book and come back to it time and time again is the way that key scientific figures are really brought to life. Kean paints a full and thoroughly unvarnished picture of famous people like Marie Curie and really makes them feel human, rather than the abstract, one-dimensional characters they are often portrayed as. It’s certainly not a textbook, but I think it does a good job of introducing the breadth of chemistry.
I recommend this book for anyone with an interest in chemistry. The author takes you on a tour of the periodic table, showcasing how a variety of elements from the notorious to the obscure have driven advancements in chemistry. The author places an emphasis on how these advancements in chemistry have impacted health, politics, economics, war and technology – and how it has not always, knowingly or unknowingly, been used for good. A focus on the societal impact of chemistry is effectively used as a vehicle to introduce higher-level concepts in chemistry that reach beyond the syllabus. The main reason that I really love this book and come back to it time and time again is the way that key scientific figures are really brought to life. Kean paints a full and thoroughly unvarnished picture of famous people like Marie Curie and really makes them feel human, rather than the abstract, one-dimensional characters they are often portrayed as. It’s certainly not a textbook, but I think it does a good job of introducing the breadth of chemistry.
Uncle Tungsten – memories of a chemical boyhood by Oliver Sacks
Suggested by Daniel Glass, Research Postgraduate Physics
 An autobiography like you’ve never seen it. Coming from a large very scientific family Oliver Sacks walks you through his life in chemistry, from a child’s fascination of science and nature to his early career days. Aside from seeing a whole range of elements and compounds in a light you never thought was possible, Sacks presents a history of chemistry and science through his journey of discovery. Although the book focuses primarily on Sacks’s chemistry adventures the book appeals to all, from the young budding scientist to a renown professor. As you turn through the pages you get to join the experiments, excitement and the memories of a chemical boyhood during war time Briton. The book portrays an admiral raw passion and excitement for the thrill and discovery of science.
An autobiography like you’ve never seen it. Coming from a large very scientific family Oliver Sacks walks you through his life in chemistry, from a child’s fascination of science and nature to his early career days. Aside from seeing a whole range of elements and compounds in a light you never thought was possible, Sacks presents a history of chemistry and science through his journey of discovery. Although the book focuses primarily on Sacks’s chemistry adventures the book appeals to all, from the young budding scientist to a renown professor. As you turn through the pages you get to join the experiments, excitement and the memories of a chemical boyhood during war time Briton. The book portrays an admiral raw passion and excitement for the thrill and discovery of science.
Periodic tales: The curious lives of the elements by Hugh Aldersey-Williams
Suggested by Dr Mel Bottrill, Deputy Head of Outreach
 As a complete nerd about the periodic table, I love this book because it showcases the human stories behind the elements. The periodic table is something that I found intimidating as a school student, but as I studied chemistry at A-Level I began to love and to realise how beautiful I found it. We often see it as a tool, concentrating on its properties and patterns, but it is so much more and this book demonstrates how much more it is. It is a tour of discovery, outlining the stories of the different discoveries of the elements, the people that discovered them and interesting and funny facts about how they are used – almost a travelogue of the elements. You don’t have to be studying chemistry to find something enjoyable about this book!
As a complete nerd about the periodic table, I love this book because it showcases the human stories behind the elements. The periodic table is something that I found intimidating as a school student, but as I studied chemistry at A-Level I began to love and to realise how beautiful I found it. We often see it as a tool, concentrating on its properties and patterns, but it is so much more and this book demonstrates how much more it is. It is a tour of discovery, outlining the stories of the different discoveries of the elements, the people that discovered them and interesting and funny facts about how they are used – almost a travelogue of the elements. You don’t have to be studying chemistry to find something enjoyable about this book!
Stuff Matters: Exploring the Marvelous Materials That Shape Our Man-Made World by Mark Miodownik
Suggested by Louise Li, Undergraduate Chemistry student
 Having never studied Materials Science at school, this booked tapped into a whole new world that I had never previously given much thought to. The blurb captured my attention instantly, and I was keen to discover more about the ordinary and not-so-ordinary materials that have shaped the lives of humanity, and continue to be developed in advanced research labs across the world.
Having never studied Materials Science at school, this booked tapped into a whole new world that I had never previously given much thought to. The blurb captured my attention instantly, and I was keen to discover more about the ordinary and not-so-ordinary materials that have shaped the lives of humanity, and continue to be developed in advanced research labs across the world.
Told in the first person, as a story of the author going about his daily routine, the book encompasses objects and matter from every aspect of life: From ornate tea-cups to dynamic jet engines, and silicon chips to the fabrics of our t-shirts. Stuff Matters is a highly entertaining read, accessible to all and as one of the first “popular science” books I ever read (that also featured in my personal statement!), I cannot recommend it enough!
CHEMISTRY - A Very Short Introduction by Peter Atkins
Suggested by Diana Tanase, Research Postgraduate Chemistry
 I love chemistry but I met plenty of people who not only struggle to understand why I love chemistry, but also question my sanity. Peter Atkins’ short introduction to the world of chemistry has been an amazing resource of defence arguments for me. Atkins is a name most chemists will recognize because he has written some amazing physical chemistry textbooks. His insight and exposure to the field make this short book a great introduction into what chemistry is and how it has revolutionised the world we live in. I recommend this book if you are getting ready to write your personal statement or if you are just trying to figure out why people study chemistry. Peter Atkins’ passion and enthusiasm really are contagious!
I love chemistry but I met plenty of people who not only struggle to understand why I love chemistry, but also question my sanity. Peter Atkins’ short introduction to the world of chemistry has been an amazing resource of defence arguments for me. Atkins is a name most chemists will recognize because he has written some amazing physical chemistry textbooks. His insight and exposure to the field make this short book a great introduction into what chemistry is and how it has revolutionised the world we live in. I recommend this book if you are getting ready to write your personal statement or if you are just trying to figure out why people study chemistry. Peter Atkins’ passion and enthusiasm really are contagious!
STEM Book List Chemistry (PDF)
Photo 1 by Walter Bichler from Pixabay; Photo 2 by Bokskapet from Pixabay; Photo 3 by Vubp from Pixabay; Photo 4 by Thomas Angus Imperial College London; Photo 5 by Michele Panzeri Imperial College London
How to lie with statistics by Darrell Huff
Suggested by Maria Portela, Undergraduate Bioengineering
 This is a book that will make you question every single statistical figure you have ever encountered. It is not intended to be a course in statistics, and in fact, there are no equations on it. Instead, it uses many examples to show how easy it is to build misleading arguments and lists several devices by which data can be manipulated (willingly or not) to force a meaningless conclusion. When I studied statistics in high school, I found it hard to break away from mathematical descriptions and understand how to apply them to the real world. This book was really helpful to put those concepts into perspective, practice spotting statistical artefacts, and rethink the way I read scientific studies. It is written in a good-humoured, fast-paced style, quite easy to follow, and heavily illustrated. However, the book is from the 50s so do bear in mind some language and examples are terribly outdated. The main points are still valid, perhaps even more, today, in our data-driven world, than they were 70 years ago.
This is a book that will make you question every single statistical figure you have ever encountered. It is not intended to be a course in statistics, and in fact, there are no equations on it. Instead, it uses many examples to show how easy it is to build misleading arguments and lists several devices by which data can be manipulated (willingly or not) to force a meaningless conclusion. When I studied statistics in high school, I found it hard to break away from mathematical descriptions and understand how to apply them to the real world. This book was really helpful to put those concepts into perspective, practice spotting statistical artefacts, and rethink the way I read scientific studies. It is written in a good-humoured, fast-paced style, quite easy to follow, and heavily illustrated. However, the book is from the 50s so do bear in mind some language and examples are terribly outdated. The main points are still valid, perhaps even more, today, in our data-driven world, than they were 70 years ago.
Humble Pi, by Matt Parker
Suggested by Ela Kemp, Makerspace Leader
What's not to like - clever people getting it wrong! ...and the consequences that follow! --tojpeg_1592817445067_x2.jpg)
Factfulness by Hans Rosling
Suggested by Alessandra Lochen, Research Postgraduate School of Public Heath
 By the late statistician, which is a data-driven look into misconceptions around global health and economic inequality. Very light and easy read for those not familiar with the topics.
By the late statistician, which is a data-driven look into misconceptions around global health and economic inequality. Very light and easy read for those not familiar with the topics.
Why does E=mc2? By Brian Cox and Jeff Forshaw
Suggested by Scott Marley, Outreach Leader
 I have to admit to being a little biased on this one, as Brian Cox and Jeff Forshaw both taught me physics at Manchester a long time ago! This is a highly readable and accessible explanation of the theory of relativity with a minimal amount of mathematics. If you want something with a bit more mathematical oomph, then go for another book by the same authors, ‘The Quantum Universe: Everything that can happen, will happen’.
I have to admit to being a little biased on this one, as Brian Cox and Jeff Forshaw both taught me physics at Manchester a long time ago! This is a highly readable and accessible explanation of the theory of relativity with a minimal amount of mathematics. If you want something with a bit more mathematical oomph, then go for another book by the same authors, ‘The Quantum Universe: Everything that can happen, will happen’.
Fermat’s last theorem by Simon Singh
Suggested by Scott Marley, Outreach Leader
 Can a book about mathematics be impossible to put down? This one is! Fermat’s last theorem reads like the most gripping of detective novels with the detectives involved spanning 400 years from Fermat to Andrew Wiles. Along the way, we meet Euler, Cauchy, Turing, Hilbert, and many other greats of the mathematical world, and see how one man’s obsessions finally cracked a seemingly unsolvable problem.
Can a book about mathematics be impossible to put down? This one is! Fermat’s last theorem reads like the most gripping of detective novels with the detectives involved spanning 400 years from Fermat to Andrew Wiles. Along the way, we meet Euler, Cauchy, Turing, Hilbert, and many other greats of the mathematical world, and see how one man’s obsessions finally cracked a seemingly unsolvable problem.
Photo 1 by Gerd Altmann from Pixabay; Photo 2 by Andrew Martin from Pixabay; Photo 3 by stokpic from Pixabay; Photo 4 by Jackie Ramirez from Pixabay; Photo 5 by Hebi B from Pixabay
Structures: Or why things don't fall down by J. E. Gordon
Suggested by Michael D Jones, Research Postgraduate Mechanical Engineering
 Structures is a brilliant introductory book into the world of structural theory. I first read it around the time I was making my applications to university to study mechanical engineering. I wanted to get an idea of the sort of subjects that would be covered in my course. This book is particularly good due to its fairly informal style. Although it focuses a lot on principles that are the bedrock of engineering analysis, it is by no means like a text book. Gordon's tone is much more conversational, and throughout the text he constantly references his own experiences alongside various other anecdotes and case studies, both from nature and the man made world. This gives the reader a good appreciation not only of how we have applied principles in order to create a wide range of structures, but also critically highlights a number of the incidents of structural failure that have led to step changes and improvements in our understanding. A must read for prospective students looking to apply for mechanical, civil, aeronautical and biomedical engineering.
Structures is a brilliant introductory book into the world of structural theory. I first read it around the time I was making my applications to university to study mechanical engineering. I wanted to get an idea of the sort of subjects that would be covered in my course. This book is particularly good due to its fairly informal style. Although it focuses a lot on principles that are the bedrock of engineering analysis, it is by no means like a text book. Gordon's tone is much more conversational, and throughout the text he constantly references his own experiences alongside various other anecdotes and case studies, both from nature and the man made world. This gives the reader a good appreciation not only of how we have applied principles in order to create a wide range of structures, but also critically highlights a number of the incidents of structural failure that have led to step changes and improvements in our understanding. A must read for prospective students looking to apply for mechanical, civil, aeronautical and biomedical engineering.
The Mars trilogy by Kim Stanley-Robinson
Suggested by Michael D Jones, Research Postgraduate Mechanical Engineering
 Comprising of Red Mars, Green Mars and Blue Mars, the trilogy is an epic tale of how humans might colonise Mars. The author has put an immense amount of effort into researching a myriad of topics that would be encountered if we were to try and start a civilization on the Red Planet, starting with the challenges faced by sending an initial colony to such a hostile world, as yet untouched by humanity, travelling right through to the politics and social issues associated with forming a new state on a different celestial body. The books not only follow the story of humanity as a whole on their journey across the solar system, but also of a number of interesting and varied protagonists, each fighting for their own vision of how society should establish itself on Mars. A fantastic read, both entertaining and thought provoking.
Comprising of Red Mars, Green Mars and Blue Mars, the trilogy is an epic tale of how humans might colonise Mars. The author has put an immense amount of effort into researching a myriad of topics that would be encountered if we were to try and start a civilization on the Red Planet, starting with the challenges faced by sending an initial colony to such a hostile world, as yet untouched by humanity, travelling right through to the politics and social issues associated with forming a new state on a different celestial body. The books not only follow the story of humanity as a whole on their journey across the solar system, but also of a number of interesting and varied protagonists, each fighting for their own vision of how society should establish itself on Mars. A fantastic read, both entertaining and thought provoking.
STEM Book List Mechanical Engineering (PDF)
Photo 1 by Thomas Angus Imperial College London; Photo 2 Courtesy of NASA Imperial College London
Brave new world by Aldous Huxley
Suggested by Helen Sharman, UK Outreach Ambassador
 Set in a futuristic social and political world, although written way back in 1931, this book made me think about how society uses science, in particular that the same knowledge can be used for good or bad purposes. It is amazingly inciteful, given that it was written way before IVF was developed and before we knew what we do about foetal development, yet it provokes thought about genetic engineering and other ways we change and adapt as humans. I really liked the way the main character held opinions based on logic that were against what everyone else had been made to think. For me, science wins over unthinking conditioning any day!
Set in a futuristic social and political world, although written way back in 1931, this book made me think about how society uses science, in particular that the same knowledge can be used for good or bad purposes. It is amazingly inciteful, given that it was written way before IVF was developed and before we knew what we do about foetal development, yet it provokes thought about genetic engineering and other ways we change and adapt as humans. I really liked the way the main character held opinions based on logic that were against what everyone else had been made to think. For me, science wins over unthinking conditioning any day!
The man who mistook his wife for a hat by Oliver Sacks
Suggested by Rebecca Sweeney, Reach Out Makerspace Assistant
 A fascinating look into the curious and bewildering effects when something in the brain goes wrong. Neurologist Oliver Sacks shares a collection of case histories of patients he has treated for bizarre neurological disorders, recounting extraordinary tales of profound amnesias, photographic memory, ‘seeing’ musical sounds, phantom limbs, and a man whose visual agnosia meant he perceived his wife as a hat. I love this book because it poignantly illustrates both the fragility of our 1.5kg brain and its remarkable ability to compensate for cognitive deficiencies, often with comical yet wondrous consequences.
A fascinating look into the curious and bewildering effects when something in the brain goes wrong. Neurologist Oliver Sacks shares a collection of case histories of patients he has treated for bizarre neurological disorders, recounting extraordinary tales of profound amnesias, photographic memory, ‘seeing’ musical sounds, phantom limbs, and a man whose visual agnosia meant he perceived his wife as a hat. I love this book because it poignantly illustrates both the fragility of our 1.5kg brain and its remarkable ability to compensate for cognitive deficiencies, often with comical yet wondrous consequences.
The ghost map by Steven Berlin Johnson
Suggested by Ahreum Jung, Invention Room Associate: Hacking and Making
 The Ghost Map: The story of London's most terrifying epidemic – and how it changed science, cities and the modern world is a book by Steven Berlin Johnson in which he describes the most intense outbreak of cholera in Victorian London and centers on John Snow and Henry Whitehead.
The Ghost Map: The story of London's most terrifying epidemic – and how it changed science, cities and the modern world is a book by Steven Berlin Johnson in which he describes the most intense outbreak of cholera in Victorian London and centers on John Snow and Henry Whitehead.
Happy accidents: Serendipity in modern medical breakthroughs by Morton A. Meyers
Suggested by Elzbieta Lauzikaite, Research Postgraduate Dept of Metabolism, Digestion and Reproduction
 An highly entertaining book on the role of serendipity in medical research, covering the most important discoveries in the 20th century. It reminded me of the importance of an open and creative mind, and that not everything in science goes according to a plan.
An highly entertaining book on the role of serendipity in medical research, covering the most important discoveries in the 20th century. It reminded me of the importance of an open and creative mind, and that not everything in science goes according to a plan.
Spillover by David Quammen
Suggested by Megan Joseph, Administrator, Student Recruitment and Outreach
 It's a book all about animal infections and the next human pandemic which is obviously very topical right now but regardless of the current situation this book is a great read!
It's a book all about animal infections and the next human pandemic which is obviously very topical right now but regardless of the current situation this book is a great read!
It focuses on specific examples of crossover events from animals to humans for certain diseases and gives you the story behind the events as well as the science.
Together: The Healing Power of Human Connection in a Sometimes Lonely World by Vivek Murthy
Suggested by Lauren Wheeler, 1st year Medical Biosciences student
 Whilst learning about human biology, I have always been fascinated by the interplay between what goes on in the body and in the mind. It’s astonishing to think that within a matter of milliseconds our thoughts and perceptions can profoundly affect our physiology, and vice versa. Together, a new book from the former surgeon general of the United States, explores what he has come to view as the greatest public health concern of our time: loneliness.
Whilst learning about human biology, I have always been fascinated by the interplay between what goes on in the body and in the mind. It’s astonishing to think that within a matter of milliseconds our thoughts and perceptions can profoundly affect our physiology, and vice versa. Together, a new book from the former surgeon general of the United States, explores what he has come to view as the greatest public health concern of our time: loneliness.
Shark Gets Cancer, Mole Rats Don't by Dr James Welsh
Suggested by Krish Gadhvi, 1st year Medical student
 This is a fascinating read on the nature of cancer and a brief look into cancer in the animal kingdom. The author prefaces the book by examining a previously popular myth (A book was previously written that encouraged people to buy shark cartilage supplements with the understanding that shark cartilage could cure or prevent cancer). If you want an introduction into cancer pathology and to examine cancer from a fresh perspective, this book will be a good fit!
This is a fascinating read on the nature of cancer and a brief look into cancer in the animal kingdom. The author prefaces the book by examining a previously popular myth (A book was previously written that encouraged people to buy shark cartilage supplements with the understanding that shark cartilage could cure or prevent cancer). If you want an introduction into cancer pathology and to examine cancer from a fresh perspective, this book will be a good fit!
The Emperor of All Maladies by Siddhartha Mukherjee
Suggested by Kyle Greenland, Research Postgraduate, Department of Surgery & Cancer
I read this book while still deciding what I wanted to study for undergraduate in Year 12. The book tells the history of cancer biology and its treatment. It highlights how far our understanding of the molecular basis of cancer has developed and how researchers have used this knowledge to design better cancer therapeutics. I particularly liked this book as I was always interested in human biology but did not want to study medicine. I think this book does a great job of emphasising how clinical medicine is underpinned by scientific breakthroughs in the lab. Would highly recommend it!
I read this book while still deciding what I wanted to study for undergraduate in Year 12. The book tells the history of cancer biology and its treatment. It highlights how far our understanding of the molecular basis of cancer has developed and how researchers have used this knowledge to design better cancer therapeutics. I particularly liked this book as I was always interested in human biology but did not want to study medicine. I think this book does a great job of emphasising how clinical medicine is underpinned by scientific breakthroughs in the lab. Would highly recommend it!
Photo 1 by Arek Socha from Pixabay; Photo 2 Alexander Lesnitsky from Pixabay; Photo 3 by Gerd Altmann from Pixabay; Photo 4 by Bob Williams from Pixabay; Photos 5-8 Imperial College London
The quantum universe: Everything that can happen does happen” by Jeff Forshaw and Brian Cox
Suggested by Joe Sykes, Research Postgraduate Mathematics
 This was the book that opened my eyes to the strange quantum aspect of physics (something that is hardly ever touched on in A level physics but underpins all of physics) and ultimately made up my mind that I needed to go to university and do physics because I needed to understand how this weird (and in my nerdy opinion very cool) quantum stuff worked. The book is very accessible as it is written for the general public and isn’t too mathematical and is very good at intriguing the reader to want to find out more.
This was the book that opened my eyes to the strange quantum aspect of physics (something that is hardly ever touched on in A level physics but underpins all of physics) and ultimately made up my mind that I needed to go to university and do physics because I needed to understand how this weird (and in my nerdy opinion very cool) quantum stuff worked. The book is very accessible as it is written for the general public and isn’t too mathematical and is very good at intriguing the reader to want to find out more.
The perfect theory: A century of geniuses and the battle over general relativity by Pedro G. Ferreira
Suggested by Renee Boling, STEM Programmes Coordinator Pre-16
 As an aerospace engineer I have always been fascinated by space and the role of gravity in the universe. When Einstein published his theory of general relativity in 1915 little did he know where it would take us. This book is the biography not of a person, but an idea. It follows the life of the theory through the brilliant physicists, mathematicians and astronomers who studied, challenged and expanded our knowledge of the universe with this theory from black holes to the quantum discoveries happening at the Large Hadron Collider today. Written for those with no science or mathematical backgrounds it is a fun and enjoyable read about the life and impact of a scientific theory.
As an aerospace engineer I have always been fascinated by space and the role of gravity in the universe. When Einstein published his theory of general relativity in 1915 little did he know where it would take us. This book is the biography not of a person, but an idea. It follows the life of the theory through the brilliant physicists, mathematicians and astronomers who studied, challenged and expanded our knowledge of the universe with this theory from black holes to the quantum discoveries happening at the Large Hadron Collider today. Written for those with no science or mathematical backgrounds it is a fun and enjoyable read about the life and impact of a scientific theory.
Reality is not what it seems by Carlo Rovelli
Suggested by Scott Marley, Outreach Leader
 This book is about the current work towards combining quantum mechanics and general relativity – a topic that many scientists would struggle with to make readable! Instead, Rovelli writes more like an author crafting a novel than a scientist trawling the depths of theoretical physics and has produced the most readable guide I’ve seen to this complex and fascinating topic. If you like this book, I can also recommend ‘The order of time’ and ‘Seven brief lessons on physics’ both by Rovelli.
This book is about the current work towards combining quantum mechanics and general relativity – a topic that many scientists would struggle with to make readable! Instead, Rovelli writes more like an author crafting a novel than a scientist trawling the depths of theoretical physics and has produced the most readable guide I’ve seen to this complex and fascinating topic. If you like this book, I can also recommend ‘The order of time’ and ‘Seven brief lessons on physics’ both by Rovelli.
The particle at the end of the universe by Sean Carroll
Suggested by Scott Marley, Outreach Leader
 Fast-moving, fascinating and oftentimes quite funny, this book beautifully covers the search for and discovery of the Higgs Boson. Carroll explains how we should think of the Universe in terms of fields rather than particles, and how symmetries and symmetry breaking set out the rules that govern the cosmos. When I first read this, I did so in two days, then had to read it again a few weeks later to cover all the things I had missed the first time!
Fast-moving, fascinating and oftentimes quite funny, this book beautifully covers the search for and discovery of the Higgs Boson. Carroll explains how we should think of the Universe in terms of fields rather than particles, and how symmetries and symmetry breaking set out the rules that govern the cosmos. When I first read this, I did so in two days, then had to read it again a few weeks later to cover all the things I had missed the first time!
Longitude by Dava Sobel
Suggested by José Monteiro, STEM Potential Coordinator
 Something I have always enjoyed is looking at maps and planning road trips by bike or car. It is difficult to get lost now we can all carry phones with GPS receivers in our pockets. Until the 18th century, many lives were lost at sea as there was not a reliable way to know a ship’s exact location. This book tells the story of the quest to solve this problem. It focuses on the life of John Harrison who worked all his life to accomplish this. You read it just like you would read a novel following Harrison’s achievements and setbacks trying to convince others that his ideas would work. More than presenting scientific knowledge, this book shows a thrilling example of personal work done when solving scientific and technical problems. It may even get some people interested in navigation and clock making!
Something I have always enjoyed is looking at maps and planning road trips by bike or car. It is difficult to get lost now we can all carry phones with GPS receivers in our pockets. Until the 18th century, many lives were lost at sea as there was not a reliable way to know a ship’s exact location. This book tells the story of the quest to solve this problem. It focuses on the life of John Harrison who worked all his life to accomplish this. You read it just like you would read a novel following Harrison’s achievements and setbacks trying to convince others that his ideas would work. More than presenting scientific knowledge, this book shows a thrilling example of personal work done when solving scientific and technical problems. It may even get some people interested in navigation and clock making!
Quantum by Manjit Kumar
Suggested by Scott Marley, Outreach Leader
 Although it covers the basic science of quantum mechanics, this book is really about the incredible characters involved in the theory’s development. Focussing on the great rivalry between Einstein and Bohr, this roller-coaster of a book follows a wide cast of characters as they try to determine the true nature of reality. It reminds us that science is carried out by real people, with all the drama and emotion that entails.
Although it covers the basic science of quantum mechanics, this book is really about the incredible characters involved in the theory’s development. Focussing on the great rivalry between Einstein and Bohr, this roller-coaster of a book follows a wide cast of characters as they try to determine the true nature of reality. It reminds us that science is carried out by real people, with all the drama and emotion that entails.
Photo 1 by Gerd Altmann from Pixabay; Photo 2 free image Pixabay; Photo 3 by 272447 from Pixabay; Photo 4 Imperial College London; Photo 5 by Mokkafuchs from Pixabay Photo 6 Imperial College London
Inferior by Angela Saini
Suggested by Medina Wane, Research Postgraduate Life Science
 Our view of what makes women and men different is shaped by many things including culture, media, and personal experience, but also science. As a biological scientist and woman in science myself, I was very curious about what science tells us about these differences. In this book, Angela Saini lays out the science, but also some of the flaws behind it. Science is often represented as being objective, but as Angela Saini explains, the science behind sex differences is muddled with historical and modern biases. Biased perceptions of women influence how science is conducted which in turn influences how we view women in society. I recommend this book for everyone as it’s very thought-provoking and easy to dip in and out of. I think it’s especially important for those interested in becoming scientists to see how much of an impact science can have and how self-critical we must be when carrying out research.
Our view of what makes women and men different is shaped by many things including culture, media, and personal experience, but also science. As a biological scientist and woman in science myself, I was very curious about what science tells us about these differences. In this book, Angela Saini lays out the science, but also some of the flaws behind it. Science is often represented as being objective, but as Angela Saini explains, the science behind sex differences is muddled with historical and modern biases. Biased perceptions of women influence how science is conducted which in turn influences how we view women in society. I recommend this book for everyone as it’s very thought-provoking and easy to dip in and out of. I think it’s especially important for those interested in becoming scientists to see how much of an impact science can have and how self-critical we must be when carrying out research.
Race after technology by Ruha Benjamin
Suggested by Ahreum Jung, Invention Room Associate: Hacking and Making, Student Recruitment and Outreach
 From everyday apps to complex algorithms, Ruha Benjamin cuts through tech-industry hype to understand how emerging technologies can reinforce White supremacy and deepen social inequity. Benjamin argues that automation, far from being a sinister story of racist programmers scheming on the dark web, has the potential to hide, speed up, and deepen discrimination while appearing neutral and even benevolent when compared to the racism of a previous era. Presenting the concept of the "New Jim Code," she shows how a range of discriminatory designs encode inequity by explicitly amplifying racial hierarchies; by ignoring but thereby replicating social divisions; or by aiming to fix racial bias but ultimately doing quite the opposite. Moreover, she makes a compelling case for race itself as a kind of technology, designed to stratify and sanctify social injustice in the architecture of everyday life. This illuminating guide provides conceptual tools for decoding tech promises with sociologically informed skepticism. In doing so, it challenges us to question not only the technologies we are sold but also the ones we ourselves manufacture.
From everyday apps to complex algorithms, Ruha Benjamin cuts through tech-industry hype to understand how emerging technologies can reinforce White supremacy and deepen social inequity. Benjamin argues that automation, far from being a sinister story of racist programmers scheming on the dark web, has the potential to hide, speed up, and deepen discrimination while appearing neutral and even benevolent when compared to the racism of a previous era. Presenting the concept of the "New Jim Code," she shows how a range of discriminatory designs encode inequity by explicitly amplifying racial hierarchies; by ignoring but thereby replicating social divisions; or by aiming to fix racial bias but ultimately doing quite the opposite. Moreover, she makes a compelling case for race itself as a kind of technology, designed to stratify and sanctify social injustice in the architecture of everyday life. This illuminating guide provides conceptual tools for decoding tech promises with sociologically informed skepticism. In doing so, it challenges us to question not only the technologies we are sold but also the ones we ourselves manufacture.
Superior by Angela Saini
Suggested by Medina Wane, Research Postgraduate Life Science
 This is a very thought-provoking read on how science has been used to justify racism historically and in modern times. Angela Saini explores the concept of ‘race’ from historical times to modern times and makes you question what you think you know about race. It’s a great read but can definitely be quite hard-hitting. I found her explanation of how science is tied to politics, money, and power very interesting because often science is thought of as separate from politics. From artificial intelligence to medicine, this book shows us how big an impact scientific racism had, and still has, on our society.
This is a very thought-provoking read on how science has been used to justify racism historically and in modern times. Angela Saini explores the concept of ‘race’ from historical times to modern times and makes you question what you think you know about race. It’s a great read but can definitely be quite hard-hitting. I found her explanation of how science is tied to politics, money, and power very interesting because often science is thought of as separate from politics. From artificial intelligence to medicine, this book shows us how big an impact scientific racism had, and still has, on our society.
STEM Book List Social Science (PDF)
Photo 1 by Petra Blahoutová from Pixabay; Photo 2 by Owen Billcliffe Imperial College London; Photo 3 by Thomas Angus Imperial College London
Outreach Newsletter
Get monthly updates about Outreach events – sign up to our newsletter
